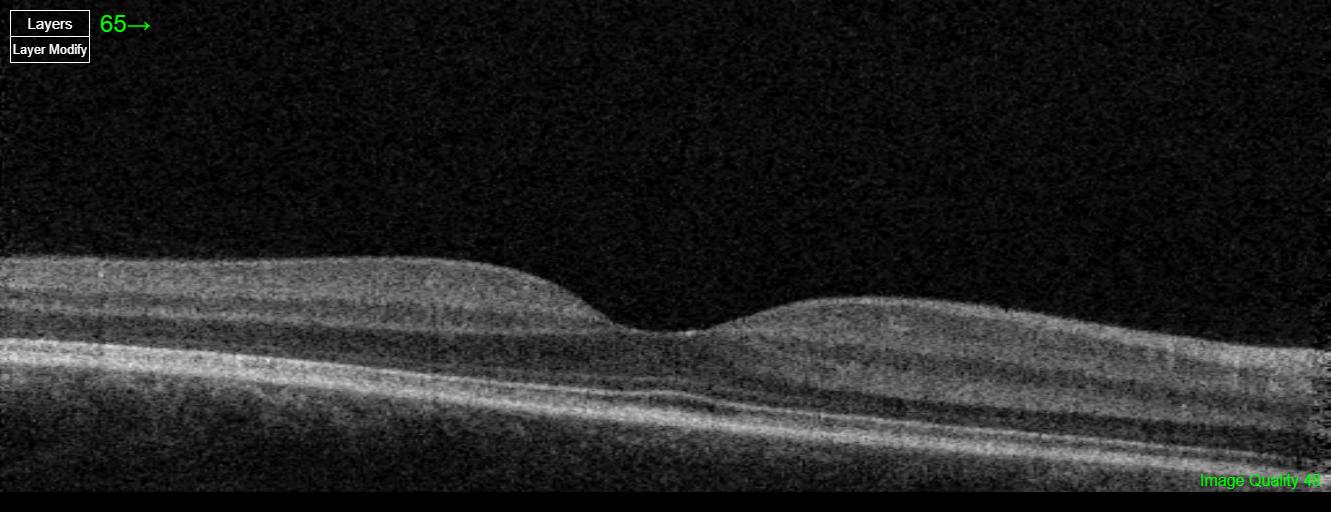
Care1 blog: Trauma-Linked Flashes
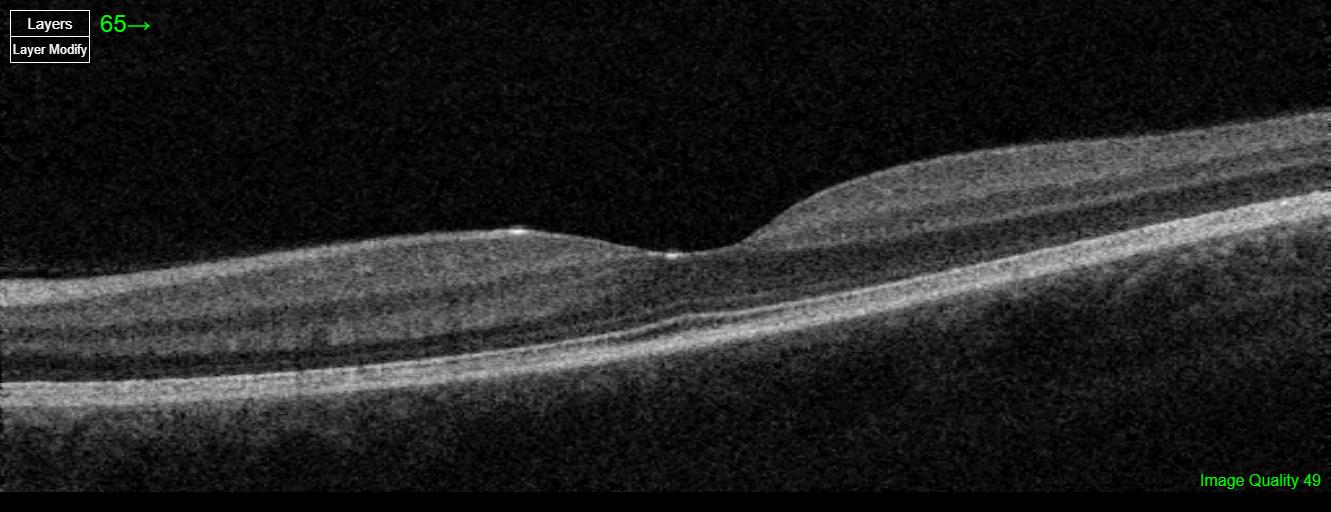
Care1 blog: Trauma-Linked Flashes

A patient presented after experiencing bright crescent-shaped flashes in their left eye (OS), following trauma in August 2024. The symptoms were becoming less frequent, but the patient remained concerned and was considering laser vision correction (LVC), which was not recommended at this time. On exam, residual intra-retinal hemorrhage was noted in the macula, and the optic discs appeared full with distinct edges. The optometrist planned a 6-month follow-up.
A retina specialist provided a virtual consult within 1-2 weeks through Care1. Scroll below to see their diagnosis.

This patient’s symptoms and imaging findings are consistent with trauma-related vitreous disruption. Fundus photos show intraretinal hemorrhages, and OCT reveals slight alteration of the foveal contour. Vitreous disruption after trauma is common and may progress to posterior vitreous detachment. The patient should be advised about warning signs of retinal detachment.
Given the increased risk of retinal detachment, especially in a post-trauma scenario, laser vision correction is not recommended. Continued observation with the referring optometrist is appropriate, and the Care1 ophthalmologist will remain involved by reviewing future imaging and clinical updates via the platform.
Posterior Vitreous Detachment (PVD) is the separation of the posterior vitreous cortex from the neurosensory retina, typically caused by age-related vitreous liquefaction and weakening of vitreoretinal adhesions. It often begins in the perifoveal region and progresses to involve the optic disc, sometimes producing a Weiss ring. While commonly asymptomatic, vitreous traction at points of strong adhesion can lead to retinal tears or detachment. PVD becomes increasingly prevalent with age and occurs earlier in myopic eyes or following trauma or intraocular surgery.
✔ Deliver the highest standards of care
✔ Increase patient satisfaction and retain patients
✔ Stimulate revenue
Posterior vitreous detachment occurs in approximately 24% of individuals aged 50–59 and increases to about 87% in those aged 80–89
Ramovecchi P, Salati C, Zeppieri M. Spontaneous posterior vitreous detachment: A glance at the current literature. World J Exp Med. 2021;11(3):30‑36. doi:10.5493/wjem.v11.i3.30